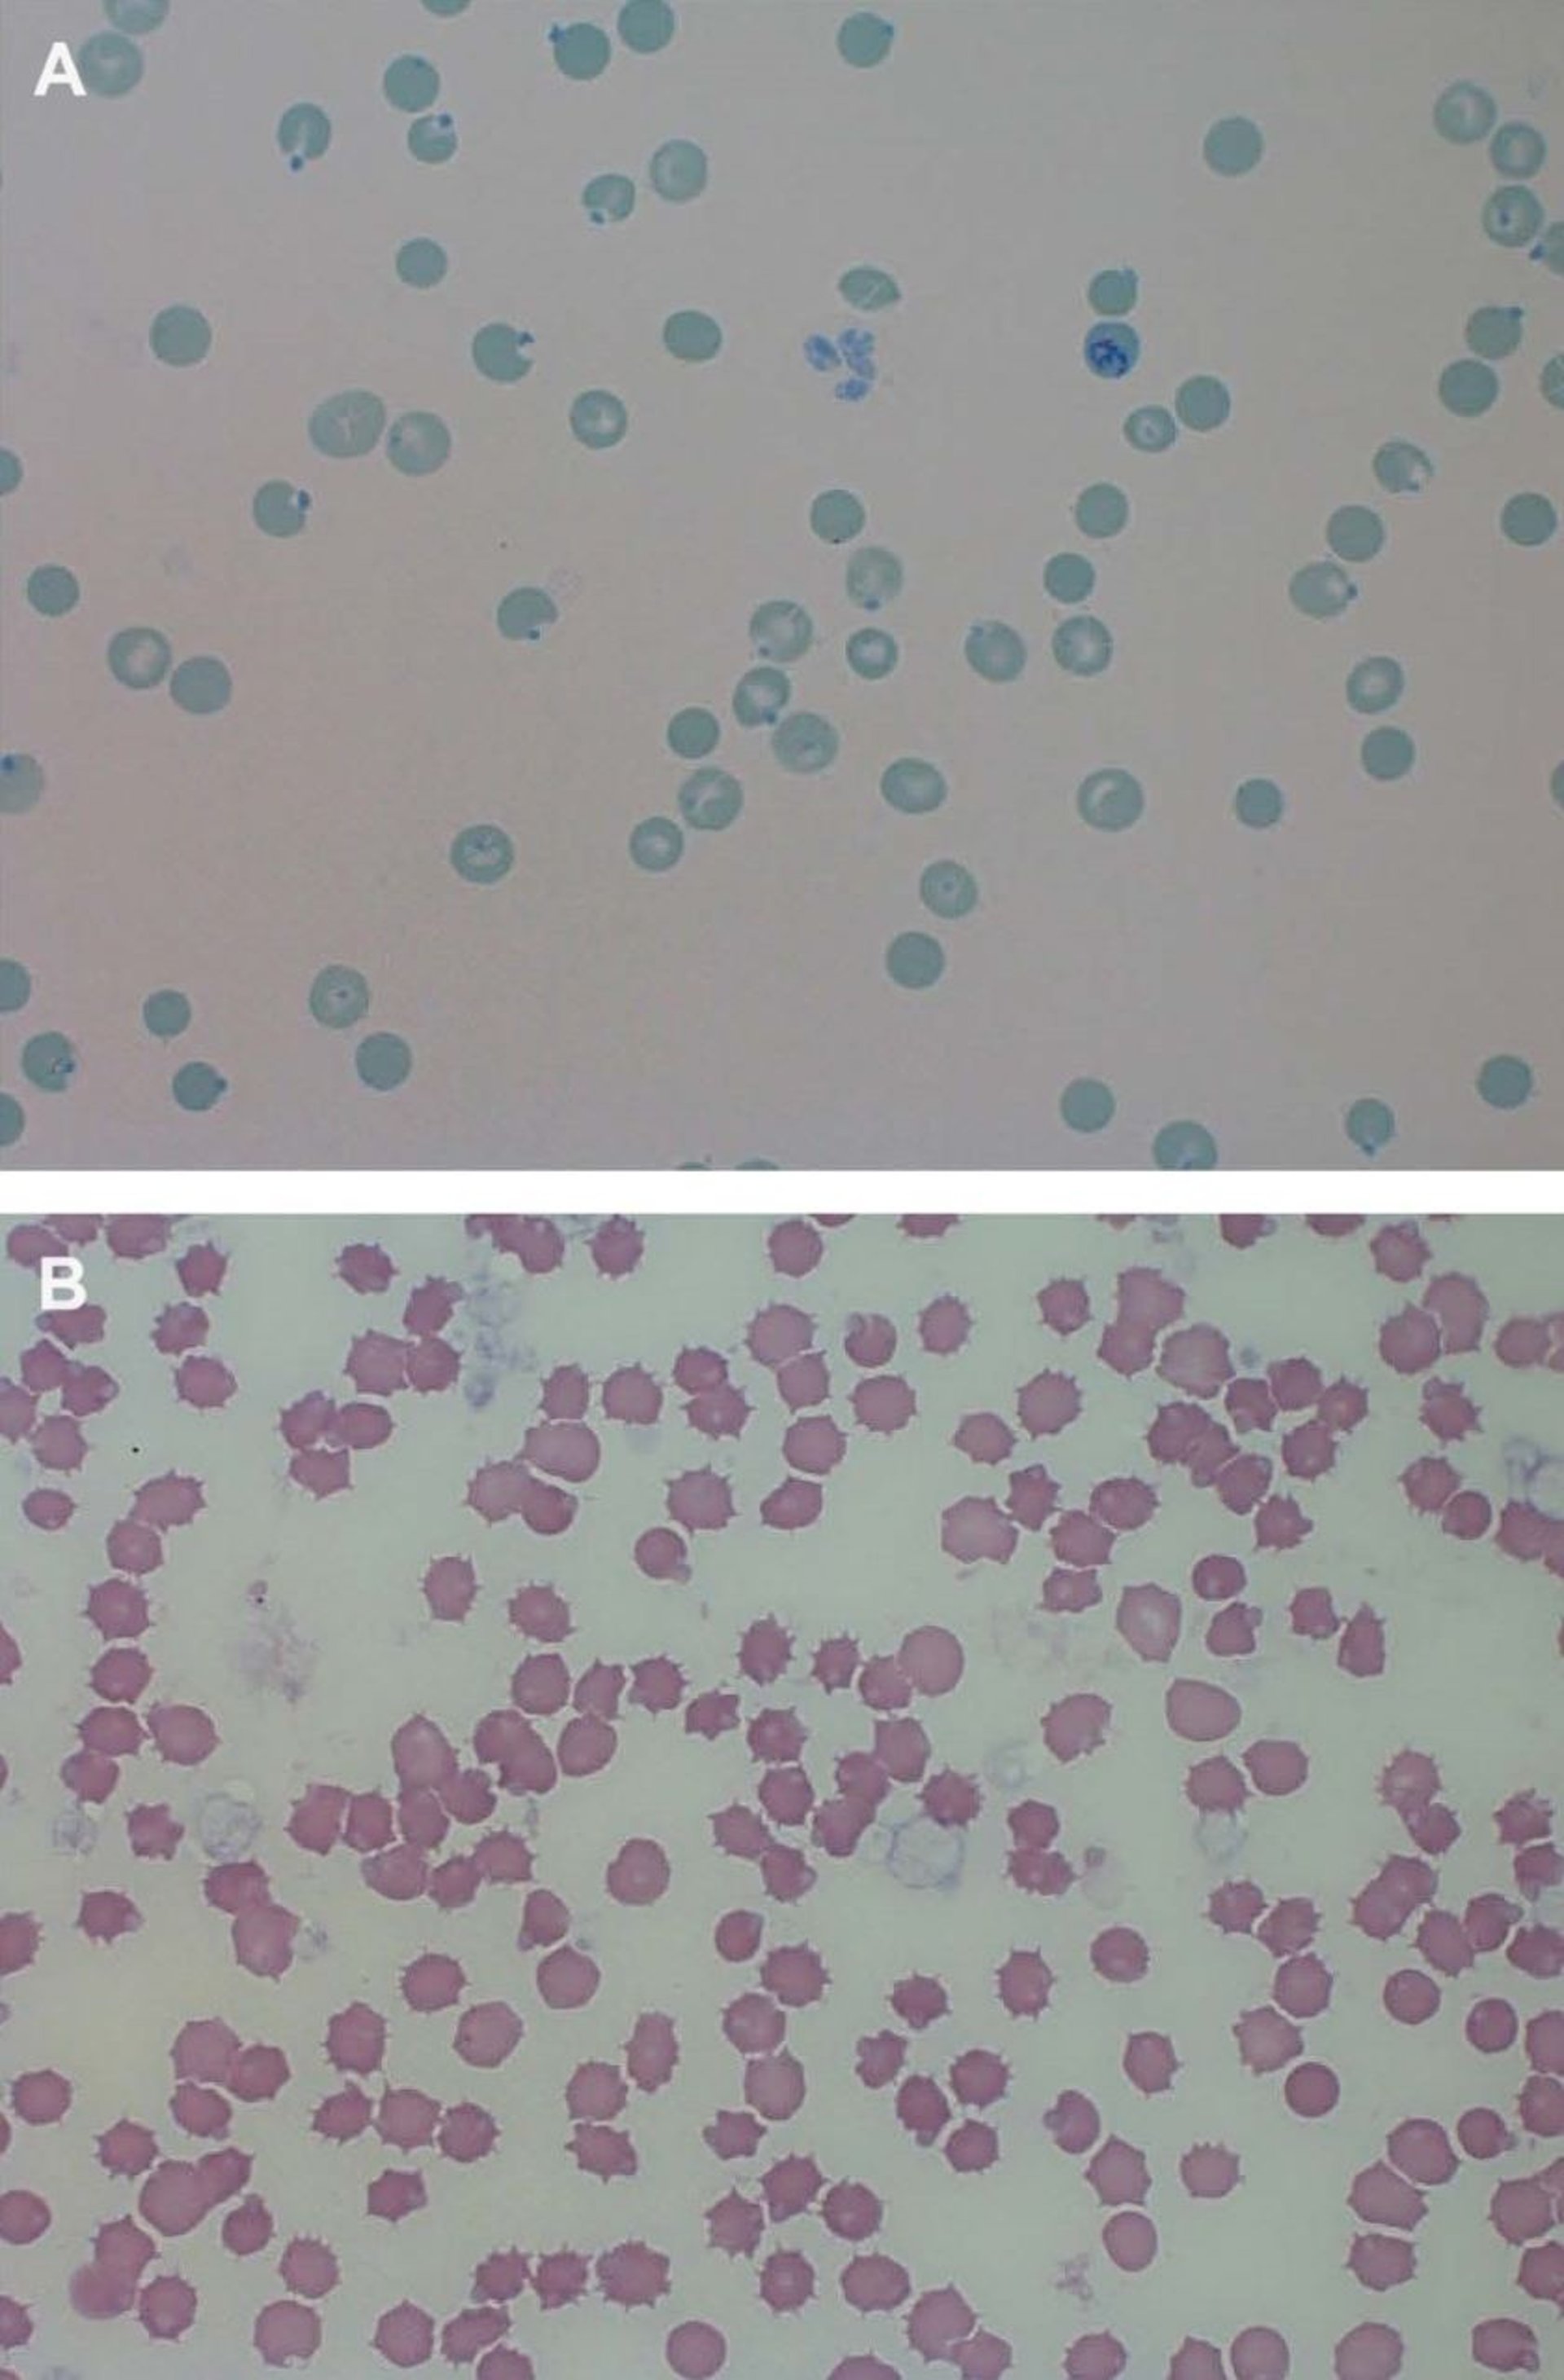
Heinz bodies, cat

Heinz bodies, cat
Photomicrographs of peripheral blood smears from a cat with Heinz body anemia. A. Heinz bodies are visible as blue inclusions on the edges of erythrocytes. New methylene blue reticulocyte stain; original magnification, 1,000X. B. Heinz bodies are visible as small refractile areas of cytoplasm. Wright-Giemsa stain; original magnification, 1,000X.
Courtesy of Dr. Devorah Stowe.
Nesses assuntos